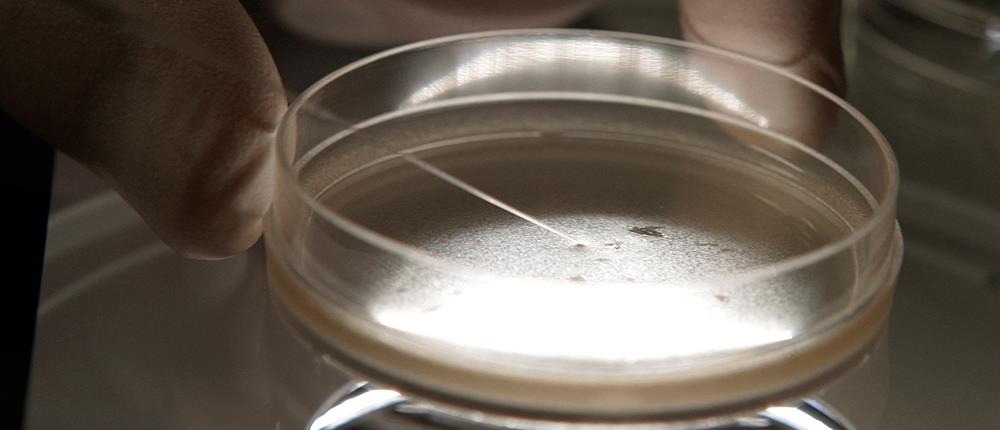

Υγεία
Έλληνας “διάβασε” άλλα 1000 γονιδιώματα μικροβίων
Πρόκειται για μικρόβια από κάθε «γωνιά» της Γης, από το νερό, το χώμα, τα φυτά, ακόμη και τα έντερα αγελάδων και τερμιτών.
Επιστήμονες από τις ΗΠΑ και άλλες χώρες με επικεφαλής έναν Έλληνα βιολόγο έκαναν ένα ακόμη βήμα για την αποκάλυψη της μεγάλης μικροβιακής βιοποικιλότητας του πλανήτη μας, καθώς έδωσαν στη δημοσιότητα τα αποκωδικοποιημένα γονιδιώματα άλλων 1.003 βακτηρίων και αρχαιοβακτηρίων (γνωστών και ως «αρχαίων»).
Παρόλο που ο αριθμός των μικροβίων σε μια μόνο χούφτα χώματος ξεπερνά τον αριθμό των άστρων του γαλαξία μας, μέχρι σήμερα οι επιστήμονες γνωρίζουν ελάχιστα πράγματα για όλο αυτό τον μικροβιακό πλούτο. Μόνο πρόσφατα έχουν αρχίσει να αξιοποιούν τις νέες τεχνολογίες γενετικής ανάλυσης για να «διαβάζουν» το DNA ολοένα περισσότερων μικροοργανισμών.
Ηγετικό διεθνώς ρόλο σε αυτή την προσπάθεια κατέχει ένας Έλληνας επιστήμονας, ο Νίκος Κυρπίδης, επικεφαλής από το 2011 του σχετικού προγράμματος στο Κοινό Ινστιτούτο Γονιδιώματος του Υπουργείου Ενέργειας των ΗΠΑ.
Στη νέα έρευνα, με επικεφαλής τον Κυρπίδη, που παρουσιάσθηκε στο περιοδικό βιοτεχνολογίας "Nature Biotechnology", παρουσιάσθηκαν 1.003 νέα γονιδιώματα, η μεγαλύτερη «φουρνιά» που έχει ποτέ δημοσιοποιηθεί μέχρι σήμερα. Πρόκειται για μικρόβια από κάθε «γωνιά» της Γης, από το νερό, το χώμα, τα φυτά, ακόμη και τα έντερα αγελάδων και τερμιτών.
Το επίτευγμα αναμένεται να βοηθήσει σε διάφορες βιοτεχνολογικές εφαρμογές στο μέλλον, καθώς η ανακάλυψη των λειτουργιών των γονιδίων, των ενζύμων και των μεταβολικών «μονοπατιών» όλων αυτών των μικροοργανισμών μπορεί να επιτρέψει την αξιοποίησή τους σε μια ευρεία γκάμα εφαρμογών σε πεδία όπως η βιοενέργεια, η βιοιατρική, η φαρμακευτική, η γεωργία, το περιβάλλον κ.α.
«Τα βακτήρια και τα αρχαία συναποτελούν το μεγαλύτερο ποσοστό της βιοποικιλότητας των έμβιων οργανισμών στη Γη. Έχουν ήδη κατακτήσει κάθε περιβάλλον στον πλανήτη μας και συνεπώς έχουν βρει τρόπους να επιβιώνουν κάτω από τις πιο αντίξοες συνθήκες, χάρη σε διαφορετικά ένζυμα και τη διαφορετική βιοχημεία τους», όπως είπε ο Κυρπίδης.
Η «Γονιδιωματική Εγκυκλοπαίδεια Βακτηρίων και Αρχαίων» (GEBA) είναι μια φιλόδοξη πρωτοβουλία του αμερικανικού υπουργείου Ενέργειας, που αποσκοπεί στην «αλληλούχιση» (ανάγνωση) του DNA πολλών χιλιάδων μικροοργανισμών, ιδίως σε ανεξερεύνητα έως τώρα «κλαδιά» του δέντρου της ζωής. Τα πρώτα 56 γονιδιώματα της μικροβιακής «Εγκυκλοπαίδειας» είχαν δημοσιευθεί το 2009.
Σήμερα είναι η κύρια ερευνητική προσπάθεια που βρίσκεται σε εξέλιξη σε αυτό το πεδίο παγκοσμίως, με την ελπίδα ότι θα προκύψουν νέες σημαντικές βιοτεχνολογικές εφαρμογές. Όπως δήλωσαν οι ερευνητές, μόλις τώρα αρχίζει να έρχεται στο φως το τεράστιο κρυμμένο δυναμικό του μικρόκοσμου.
Ο Ν. Κυρπίδης αποφοίτησε το 1988 από το Τμήμα Βιολογίας του Αριστοτελείου Πανεπιστημίου Θεσσαλονίκης και το 1996 πήρε το διδακτορικό του στη μοριακή βιολογία και βιοτεχνολογία από το Πανεπιστήμιο Κρήτης.
Στη νέα μελέτη συνεργάσθηκαν επίσης οι Μιχάλης Χατζηθωμάς και Γιώργος Παυλόπουλος, επίσης ερευνητές του Κοινού Ινστιτούτου Γονιδιώματος του Υπουργείου Ενέργειας των ΗΠΑ.
Ακολουθήστε το antenna.gr στο Google News και μάθετε πρώτοι όλες τις ειδήσεις!

